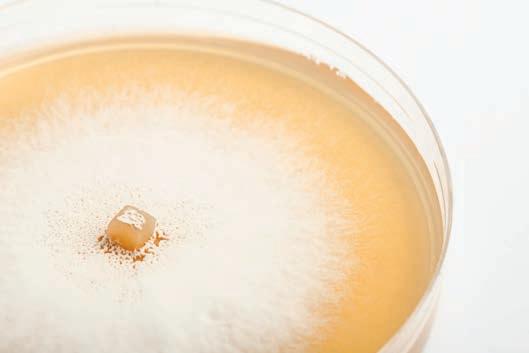

ITMA 2023 abre el registro online de visitantes Cabecera
Greenpeace saca a la luz los trapos sucios de SHEIN
Ernesto Maurer, presidente de CEMATEX Sostenibilidad
Entrevista
ecommerce
Nº 285 Año XXXIX Diciembre 2022
El futuro del
en España
Sostenibilidad Texfor desarrolla un curso centrado en la sostenibilidad de la cadena de valor.
Opinión
“Cinco tendencias de consumo para las que empresas y consumidores deberán prepararse”, por Mónica Mendoza. 8
Economía
Euratex califica de “amarga decepción” la última proposición de la Comisión Europea.


Cabecera
El sector algodonero en España presenta un crecimiento sin márgenes.
DIRECTOR
José Martín jm@astoriaediciones.es
REDACCIÓN
Francesc M. Almena falmena@astoriaediciones.es

PUBLICIDAD
David Martín dmartin@astoriaediciones.es
Ropa de Casa
Heimtextil selecciona los productos para los visitantes del sector contract.


Made in Portugal KIDS MODAPORTUGAL, juntos por un futuro mejor #togetherforthefuture.

Moda La gran semana del lifestyle vuelve en febrero a Ifema Madrid.

Distribución El futuro del ecommerce en España.

Síguenos en:
ADMINISTRACIÓN Y SUSCRIPCIONES admin@astoriaediciones.es
MAQUETACIÓN Y DISEÑO Diego Peña produccion@astoriaediciones.es
NOTICIERO TEXTIL no comparte necesariamente la opinión expresada por sus colaboradores.
Edita
Av. Meridiana, 36, ent. 3a BARCELONA - 08018 Tel. 93 463 70 62 www.astoriaediciones.es info@astoriaediciones.es
6
16
44
31
48
56
34 Entrevista Ernesto Maurer, presidente de CEMATEX. 40
NoticieroTextil | Diciembre 2022 2 SUMARIO
Obtén información de unos 1.500 fabricantes líderes y ve demostraciones de maquinaria en directo
Colabora y haz crecer tu negocio a través de la digitalización y la sostenibilidad
Prepárate su negocio para el futuro con las mejores soluciones para mantenerte por delante de tu competencia
Accede a ITMAconnect, el nuevo hub de aprovisionamiento y conocimiento para la comunidad textil mundial disponible durante todo el año












El registro de visitantes ya está abierto! Escanea el código QR para descubrir por qué tienes que visitar ITMA 2023.
AMEC AMTEX (España)
BTMA (Reino Unido) GTM (Países Bajos) SWISSMEM (Suiza)
ACIMIT (Italia)
T:
6849 9368 E: info@itma.com Conecta con nosotros @ ITMA2023 Escanea para obtener más información Propietario de la feria Organizador de la feria Asociaciones CEMATEX
información, colabora y prepara
SYMATEX (Bélgica) TMAS (Suecia) UCMTF (Francia) VDMA (Alemania)
+65
Obtén
tu negocio para el futuro en la mayor feria internacional de tecnología textil y de la confección del mundo
La hora de la verdad
2022 llega a su fin. Aunque aun no tengamos la perspectiva para saber cómo lo juzgará la historia, no cabe duda de que la invasión de Ucrania por parte de Rusia será, quizá, el hecho que lo fije en nuestra memoria, confiando, eso sí, en que no sea considerado el año precursor de un conflicto a escala más global…
En otra órbita, el año que se nos va también podrá ser recordado como el que nos devolvió la ansiada “normalidad” tras la pandemia, que hemos podido disfrutar en todos los ámbitos, desde el más personal hasta el profesional, especialmente en la segunda mitad del año, cuando hemos vuelto a celebrar todo tipo de reuniones familiares y con amigos sin ningún tipo de restricciones…y también ferias y otros eventos en el campo profesional, que han recuperado la presencialidad tras dos años de continuos vaivenes entre suspensiones, aplazamientos en una espiral demoníaca que nos hizo a todos ir de cabeza. Porque, aunque muchos eventos ya se habían desarrollado -en formato digital o híbrido- es en estos últimos meses del año cuando hemos podido recuperar el valor del contacto humano de forma muy parecida a como lo vivíamos antes del horror generado por la mayor crisis sanitaria que recordábamos en generaciones.
 Francesc M. Almena Redactor falmena@astoriaediciones.es
Francesc M. Almena Redactor falmena@astoriaediciones.es
2023 tendría que ser, por tanto, y esperando que ningún otro acontecimiento lo trunque, el de la normalidad absoluta al menos en este ámbito. Desgraciadamente, guerras, inflación, crisis energética son términos que parece que nos van a seguir acompañando. Sin restarle gravedad a estas materias, no son nada con lo que no hayamos convivido con anterioridad. Por tanto, las ferias, nacionales e internacionales, se van a enfrentar a la hora de la verdad, la de comprobar si regresan a los estándares -o similares- de 2019 o, si definitivamente, el escenario ha cambiado. Calibraremos si, en su formato tradicional, siguen siendo un instrumento realmente válido para la promoción y expansión de las empresas o si, pasado el primer momento de la euforia generada por el reencuentro, ya no lo son.
Ojalá que sigan siendo plataformas relevantes, porque añaden ese plus de contacto humano tan necesario entre los profesionales y que el mundo digital ya ha demostrado que no nos puede ofrecer por mucho que sea el modelo dominante.
NoticieroTextil | Diciembre 2022 4 BILLETE
Partner-up para el suministro de la moda




06 – 08.02.2023 PARIS, LE BOURGET FRANCIA texworldevolution-paris.com
Cinco tendencias de consumo para las que empresas y consumidores deberán prepararse
El macroentorno actual va a definir en gran medida las tendencias de consumo; estamos en un entorno que cumple con las siglas V.U.C.A (Volatilidad, Incertidumbre [Uncertainty en inglés], Complejidad y Ambigüedad) mediatizado por la guerra Rusia-Ucrania, la falta de materias primeras, el cambio climático, el encarecimiento de los transportes, la falta de personal cualificado en algunos sectores, la transformación digital, la era post-covid y la crisis de los semiconductores.
Por lo que, en 2023, se seguirá viendo la continuación de las innovaciones y desarrollos en tecnologías transformadoras como la inteligencia artificial (IA), el internet de las cosas (IoT), la realidad virtual y aumentada (VR/AR), la computación en la nube, el blockchain y los protocolos de red superrápidos como el 5G. Y evidentemente, el comercio electrónico seguirá creciendo.
Las tendencias del consumidor que tendrán mayor impacto serán:
LA POBLACIÓN SE ESTÁ POLARIZANDO
Es una tendencia que se lleva observando en los últimos años, pero ahora se
está intensificando más. La clase media tiende a ser la más castigada, “los ricos cada vez son más ricos” y la clase media-baja posiblemente pase a baja. Pero, aunque esta frase sobre los ricos podría parecer un cliché, tiene su base científica en diversos estudios del reconocido economista francés Thomas Piketty, experto en desigualdad económica.

TENDENCIA DEL CONSUMIDOR CON EL CAMBIO CLIMÁTICO Y EMPRESAS MÁS HUMANAS
Las tendencias de consumo durante 2022 indican que los compradores quieren verse cada vez más reflejados en la comunicación de las marcas y eso también compra. De hecho, el pasado mes de noviembre ha resultado ser uno de los más cálidos de las últimas décadas. Con los ODS (Objetivos de Desarrollo Sostenible) y una población cada vez más sensibilizada hacia la sostenibilidad y las empresas transparentes y “humanas”, el consumidor cada vez valorará más trabajar con empresas que cumplan con alguno de los ODS con los que dicho consumidor se sienta identificado. Además, el plan de Recuperación, Transformación y Resiliencia del Gobierno de España incluye justamente el tema de la transición ecológica, entre otros.
NoticieroTextil | Diciembre 2022 6 OPINIÓN
Mónica Mendoza, licenciada en Psicología por la Universidad Autónoma de Barcelona (UAB)
A NIVEL DE EMPRESA
Con un entorno tan incierto se observa que los empresarios/empresarias, estarán bastante indecisos o bloqueados a la hora de tomar decisiones de inversión importantes, que tengan retornos de la inversión (ROI’s) a más de 2-3 años vista como resultado de esa incertidumbre que genera este entorno tan cambiante.

MAYOR CONSCIENCIA POR LA SALUD MENTAL Y FINANCIERA
Los consumidores son más conscientes de la importancia que tienen el bienestar, la salud mental y la estabilidad; la felicidad, el equilibrio social y la conciencia medioambiental. Después de la crisis del covid se ha empezado a ver la tendencia apodada como “la gran renuncia” y no es más que la renuncia voluntaria al puesto de trabajo, entre otras razones por la pérdida de entusiasmo con las tareas, la poca progresión que pueden tener los empleados dentro de la estructura organizativa de la empresa o por la falta de empatía y comprensión que tienen dentro de la misma. Los trabajadores están priorizando
organizaciones donde puedan compaginar su vida personal y profesional, donde quizás cobren salarios ligeramente inferiores en aras de mayor libertad, creándose nuevas oportunidades de negocio dentro de este perfil en auge.
EL METAVERSO
Aunque ahora se encuentre en horas bajas debido a la recisión del contexto actual en todos los mercados, este es, sin duda, uno de los temas que más darán que hablar en los próximos años. Y es que puede ser que nos encontremos en un momento histórico muy parecido a cuando empezó a entrar internet en nuestras casas. Viendo los datos de su TAM, o tamaño del mercado, no para de crecer y, además, según el Dr. Mervyn G. Maistry, el reconocido fundador de Kintaro Capital, se estima que, para antes del 2030, el mercado relacionado con el metaverso mueva unos 8 trillones de dólares.
7 OPINIÓN NoticieroTextil | Diciembre 2022
La clase media tiende a ser la más castigada, “los ricos cada vez son más ricos” y la clase media-baja posiblemente pase a baja
ECONOMÍA
Euratex califica de “amarga decepción” la última proposición de la Comisión Europea
En un comunicado, Euratex ha subrayado que el plan de la Comisión Europea de proponer un tope de precios para el gas al por mayor en 275 euros/MWh es una “amarga decepción” para los fabricantes europeos de productos textiles y de confección.

El martes, Euratex declaró en una carta a la presidenta de la CE, Ursula von der Leyen, que cualquier tope de precios por encima del nivel de 80€/MWh no ayudaría a la industria de la UE -al sector textil en particular- a sobrevivir a la crisis actual. De hecho, ya en julio de 2021, el precio del gas al por mayor en la UE estaba por debajo de los 30€/MWh.
Ahora, la industria de la UE se enfrenta a unos precios del gas y de la energía que han superado cualquier capacidad de reacción: desde el récord de 320€/MWh del pasado agosto, el precio ha
llegado a 127€/MWh en la actualidad. Aun así, es más de un 300% que los precios habituales.
La propia existencia de la industria europea está en juego y con ella la agenda europea de sostenibilidad, y la capacidad de Europa para aplicarla. Además, Europa perderá su autonomía estratégica, que garantiza la disponibilidad de bienes y servicios esenciales en el mercado interior europeo. Si seguimos por este camino, la UE pronto se convertirá en totalmente dependiente de las importaciones extranjeras sin poder aplicar su agenda de sostenibilidad, y mucho menos liderar la transición a una economía circular en la escena internacional.
Artículo completo en
NoticieroTextil | Diciembre 2022 8
La Asamblea de Fedecon y Confederación ModaEspaña se focaliza en los retos de futuro
Las asambleas de FEDECON y Confederación ModaEspaña se han celebrado la tarde del 22 de noviembre en el Palacio de Santoña de Madrid. Ángel Asensio, presidente de ambas asociaciones, y Carmen Torres, secretaria general, han presentado los resultados del último ejercicio, así como las partidas económicas y las actividades previstas para realizar durante el año 2023.

Tras la votación para los cargos representativos de la Confederación y su proclamación, Ángel Asensio ha aprovechado su reelección para agradecer la confianza depositada en su persona y ha querido incidir en los objetivos para los próximos tres años: “Tenemos muchos retos por delante, pero nuestro fin es defender los intereses de nuestro sector. Tenemos que apostar por el valor añadido, elevar el tamaño medio de la PYME española, avanzar hacia la sostenibilidad del sector, su internacionalización y digitalización”. Joan Canals y Félix Bellido también han sido reelegidos como vicepresidentes.
Durante la jornada, Pablo Conde, director de Moda, Hábitat e Industrias Culturales del Instituto de Comercio Exterior-ICEX , ha presentado el Plan Sectorial de ModaEspaña para 2023 en el que apoyarán 33 Planes. Además, ha señalado sus nuevos retos: la sostenibilidad, el e-commerce, el marketing digital y los nuevos canales de distribución. Almudena Segado, responsable de promoción exterior de la Federación, ha hecho hincapié durante su intervención en la importancia de la industria de la moda como motor económico.
Con la intervención del asesor corporativo del Observatorio, José Monzonís, se han resuelto las dudas sobre qué es el Observatorio Textil y Moda (OTYM), en qué se ha venido trabajando desde su creación y los próximos pasos a seguir.
Artículo completo en
NoticieroTextil | Diciembre 2022 9
Nextil obtuvo un EBITDA ajustado de 3,3 millones de euros en los nueve primeros meses del año

El Grupo obtuvo en los nueve primeros meses del año un EBITDA ajustado de 3,3 millones de euros, frente a los 3,8 millones de euros del mismo periodo del año anterior. El margen de EBITDA se mantuvo en el 8,5% a pesar de un contexto económico difícil por la guerra en Ucrania y el alza del precio de las materias primas y la energía.
Los gastos extraordinarios por la puesta en marcha de la nueva planta del grupo en Guatemala impactaron en el EBITDA contable, que fue de 2,4 millones de euros. Aun así, el EBIT de este periodo fue positivo en 0,1 millones de euros, frente al resultado cero del mismo periodo de 2021.
La facturación hasta septiembre fue de 39,1 millones de euros frente a los 44,9 millones registrados en el mismo periodo del año pasa-
do debido a la desaceleración de la actividad comercial por la inestabilidad internacional, que está generando incertidumbre en los clientes y ralentizando los pedidos.
En cualquier caso, la apertura de la fábrica en Guatemala está permitiendo cerrar acuerdos con grandes corporaciones norteamericanas, hasta ahora inaccesibles, que desean trasladar sus producciones asiáticas a Centroamérica.
Respecto a la deuda financiera neta, en septiembre ascendía a 57,7 millones de euros, un 4% inferior a la cifra registrada en diciembre de 2021.
Artículo completo en
NoticieroTextil | Diciembre 2022 10 ECONOMÍA
Ana Rodríguez, al frente de la MBFWM
Ana Rodríguez, profesional de larga trayectoria al frente de los eventos de moda y tendencias de Ifema Madrid, pasa a hacerse cargo de la organización de Mercedes-Benz Fashion Week Madrid

Ifema Madrid ha designado una persona con perfil especializado en la organización y dirección de convocatorias de moda, para incorporarse a la gestión de un evento de amplio reconocimiento como es la MBFWM y asumir y profundizar en los objetivos estratégicos de internacionalización, profesionalización y digitalización que tiene ante sí la Pasarela de Moda de España.

La pasada edición de MBFWM, la primera con
aforo completo tras la pandemia cerró su 76ª edición con una excepcional acogida y la participación de grandes nombres y nuevos talentos. Una edición en la que se dieron cita 41 diseñadores: 21 firmas consagradas, 10 creadores emergentes en la Pasarela Allianz EGO, y 10 desfiles OFF.
Mercedes Benz Fashion Week Madrid celebrará su 77º edición de 15 al 19 de febrero de 2023 en el Pabellón 14.1 de Ifema Madrid, y en distintas localizaciones de la ciudad de Madrid.
leído hoy?
¿lo has
diario digital. Gratuito sin zonas reservadas NoticieroTextil | Diciembre 2022 11 ECONOMÍA
La Escuela de Artes y Técnicas de la

inaugura su nueva sede en Barcelona
Moda
La Escuela de Artes y Técnicas de la Moda (EATM) de Barcelona estrena una nueva sede en la calle Diputación 337 bajo la dirección del estilista y antiguo alumno de EATM Jaume Vidiella. Ubicada históricamente en els Jardinets del Paseo de Gracia, donde se instaló en 1987, este cambio de sede culmina también un cambio en la dirección de la escuela y la Fundación del Diseño Textil (FUNDIT) que la gestiona.
Este 2022, la FUNDIT, fundación también propietaria de la Escuela Superior de Diseño ESDi, ha renovado completamente su Patronato, hecho presidente a Carles Casanovas y nombrado directora general a Georgina Bombardó.
“El cambio de local también responde a una necesi-
dad física de espacio y nuevos equipamientos, ante la ampliación de la oferta formativa de la escuela y la cantidad de alumnado, que ha crecido exponencialmente en los últimos dos años”, remarcan.
Actualmente, en EATM se imparten los Ciclos Formativos de Grado Superior en Estilismo de Indumentaria y de Asesoría de Imagen Personal y Corporativa, y es la sede en Barcelona de la Escuela Superior de Diseño ESDi, que está ubicada en la ciudad de Sabadell.
Artículo completo en
NoticieroTextil | Diciembre 2022 12 ECONOMÍA
Lola Casademunt renueva su sede central

La firma de moda y accesorios para la mujer ha inaugurado las nuevas instalaciones de sus headquarters en Cardedeu (Barcelona). Las nuevas instalaciones alcanzan los 3.200m2 para dar respuesta al crecimiento de la compañía desde principios del 2021.
Desde finales del 2020, la compañía inició todo su plan de reposicionamiento, renovación de imagen y expansión. Todo este proyecto comenzó a dar sus frutos ya a principios del 2021; un año muy fructífero: la firma cumplió su 40 aniversario, desfiló en las dos pasarelas nacionales oficiales – como son MBFWM y 080 Barcelona Fashion -, lanzó su primera campaña de imagen, Call me Lola con Nieves Álvarez como protagonista, e inició su plan de expansión internacional. Esta evolución lleva a la compañía a prever que multiplicará su facturación por tres a finales del 2022 (25 millones de euros).
El nuevo espacio está concebido en cuatro plantas, con dos grandes open spaces; alberga oficinas centrales de finanzas y administración, IT, recursos humanos, logística, retail, wholesale, ecommerce, diseño, compras, control de calidad, almacén, marqueting y comunicación, showroom y tienda piloto.
La parte logística de la compañía se externalizó con un socio experto con el fin de poder hacer frente a este crecimiento. Asimismo, para su construcción se ha tenido en cuenta el ahorro energético, instalando aislamientos y, en breve plazo, pretenden colocar placas solares.
Artículo completo en
NoticieroTextil | Diciembre 2022 13 ECONOMÍA
Proyecto AGROMATTER
Establecimiento de una RED CERVERA para el desarrollo de materiales técnicos altamente sostenibles derivados de subproductos o residuos de la industria agrícola y de las operaciones de conservación de espacios naturales.
Antecedentes
En julio de 2021, AITEX fue reconocido como Centro de Excelencia CERVERA por parte del CDTI, Centro para el Desarrollo Tecnológico Industrial, mediante la concesión de la propuesta AGROMATTER presentada en la convocatoria de ayudas destinadas a Centros Tecnológicos de Excelencia “Cervera”, en el marco del Programa Estatal de Generación del Conocimiento y Fortalecimiento Científico y Tecnológico del Sistema de I+D+I, del Plan Estatal de Investigación Científica y Técnica y de Innovación 2017-2020.
Dicha propuesta se centra en la constitución de una Agrupación formada por cinco Centros Tecnológicos altamente complementarios en los ámbitos agrícola, biotecnológico y de ciencia de materiales: AITEX, ITENE, ANDALTEC, CTAEX y CTNC.
Objetivos
La Agrupación CERVERA AGROMATTER tiene por objetivo la constitución de una red de Centros Tecnológicos de Excelencia científicotécnica en el ámbito de la Economía Circular aplicada al desarrollo de materiales biobasados para aplicaciones técnicas y alcanzar así, un posicionamiento como centros de I+D de referencia tanto a nivel nacional como internacional, de manera que redunde en

un crecimiento en proyectos de I+D y en acciones de transferencia de tecnología al tejido empresarial.
Esta agrupación centra sus capacidades tecnológicas actuales y futuras en el estudio de valorización de residuos y subproductos del ámbito agrícola en el desarrollo de nuevos materiales de bajo impacto medioambiental, de fácil reciclabilidad y con un ciclo de vida perfectamente definido para las aplicaciones objetivo inicialmente previstas. El fin último de la Agrupación CERVERA AGROMATTER es la dinamización de los sectores industriales representados por los centros tecnológicos que la conforman a través de la transferencia de tecnología y conocimiento técnico, propiciando nuevas oportunidades de negocio relacionadas con la temática de esta Iniciativa.


Rol de AITEX en el proyecto Agromatter
El papel de AITEX en este proyecto es el de coordinación de la Red, además de aumentar el nivel de conocimiento en el proceso de desfibrilación, el proceso de hilatura de biopolímeros derivados de fuentes vegetales, la fabricación de no tejidos mediante el uso de distintas tipologías de residuo, la fabricación de materiales símil-madera a partir de residuos agrícolas y agroforestales, la implementación de colorantes naturales derivados de residuos agrícolas en procesos de tintura textil sostenible,
así como, la implementación de principios activos naturales derivados de residuos agrícolas en procesos de cosmética.
Resultados obtenidos hasta la fecha
Una de las tecnologías aplicadas para el desarrollo de soluciones AGROMATTER es el proceso de fabricación de no tejidos por vía húmeda, wet-laid. Se trata de una técnica de bajo coste que permite la obtención de no tejidos de elevada homogeneidad siempre y cuando las fibras utilizadas para su fabricación tengan la capacidad de dispersarse en fluidos. En este caso, las fibras textiles son suspendidas en un medio acuoso, y a continuación son depositadas en una cinta transportadora que conduce la lámina a la estación de consolidado por temperatura de la tela no tejida.


Algunas de las especificaciones técnicas propias de la planta piloto de wet-laid que posee AITEX son las siguientes:

• Longitudes de fibras de hasta 18 mm.
• Ancho fijo: 500 mm
• Velocidad formación de 1 – 10 m/s
Las materias primas susceptibles de ser utilizadas en procesos wet-laid pueden presentar una naturaleza química muy variada, de ahí su idoneidad para dar una segunda vida a los residuos agroalimentarios/agroforestales.
Tecnología de desarrollo de no tejidos por wet-laid de AITEX
Algunos de los residuos con los que se está trabajando en el proyecto AGROMATTER para el desarrollo de no tejidos provienen de la industria del olivar, desde los residuos de poda hasta los subproductos de la industria oleícola.
Conclusiones
Hasta la fecha, se ha verificado la viabilidad técnica de las tecnologías seleccionadas para el desarrollo de soluciones AGROMATTER con diversos tipos de residuos agroalimentarios. Entre dichas soluciones se encuentra el desarrollo de no tejidos por vía húmeda (wetlaid), con los que se han obtenido propiedades de aislamiento acústico frente a determinados rangos de frecuencia.

Asimismo, se han llevado a cabo diversas acciones que permiten la transferencia del conocimiento adquirido a las empresas y el posicionamiento de la Agrupación como alianza de referencia en el ámbito nacional e internacional.
Agradecimientos
Este proyecto está financiado por el CDTI (Centro para el Desarrollo Tecnológico Industrial), a través del Ministerio de Ciencia e Innovación, en el marco de ayudas destinadas a Centros Tecnológicos de Excelencia “Cervera” (Expediente: CER-20211013)



CABECERA
El sector algodonero en España presenta un crecimiento sin márgenes

Tras un periodo de incertidumbre provocada por la pandemia del COVID-19, la producción industrial repuntó y retomó su actividad para acercarse a niveles previos a la pandemia. Sin embargo, la crisis por los incrementos desmesurados de los precios de la energía, las materias primas y del transporte, junto a una situación de desabastecimiento, han provocado que la actividad industrial se ralentizara de nuevo y situara a las empresas textiles en una situación compleja y delicada
Desde Cityc se prevé que, en el ámbito del comercio exterior, las ventas algodoneras realizadas en el extranjero sumen en el año 2022 unos 1.140 millones de €, frente a los 1.051 alcanzados en 2021.
El principal cliente sigue siendo Marruecos, ya que las ventas al país representaron el 28% del
total, seguido de Italia (10%), Francia (9%), Portugal (9%) y Alemania (6%).
En cuanto a las importaciones de la industria algodonera, el volumen total de compras en el extranjero se prevé que alcancen los 1.321 millones de € frente a los 973 millones de € del 2021.
Los mayores proveedores fueron Pakistán, que representa el 21% de las compras totales, al que sigue China con el 17%, Turquía con el 16%, Italia 11% y Portugal 11%.
Artículo completo en
NoticieroTextil | Diciembre 2022 16

ITMA 2023 abre el registro online de visitantes
La plataforma de registro de visitantes online de ITMA 2023 ya está abierta. Los visitantes pueden disfrutar de tarifas anticipadas hasta el 7 de mayo de 2023 si compran pases en www.itma.com.
El pase de un día cuesta 40 euros, y el de siete días, 80 euros. Los estudiantes pueden visitar la exposición del 10 al 14 de junio de 2023 con una tarifa especial de 25 euros por un pase de 5 días. Los miembros de las organizaciones de apoyo de ITMA 2023 también pueden disfrutar de una tarifa especial para grupos. Hasta la fecha, la exposición ha conseguido el apoyo de más de 140 asociaciones comerciales y profesionales.
Los visitantes pueden inscribirse en las conferencias y foros de la ITMA, y solicitar una carta de invitación al pedir su pase si necesitan un visado para entrar en Italia.
Además, los visitantes podrán acceder a ITMAconnect, la recién estrenada plataforma en línea a partir del 8 de marzo de 2023, para planificar su visita a la feria. Podrán explorar los espacios digitales de los expositores y concertar citas para visitar los stands en la exposición de Milán.
Artículo completo en

NoticieroTextil | Diciembre 2022 18 CABECERA
Buenas perspectivas para Texworld Evolution de Febrero con 750 expositores confirmados
La edición de febrero de 2023 de Texworld Evolution, que se celebra en París del 6 al 8 de febrero, muestra perspectivas prometedoras.
Gracias a las 750 empresas esperadas, el total de reservas han alcanzado ya el 70% del nivel prepandémico de febrero de 2019. Los habituales expositores chinos se vuelven a encontrar como uno de los principales países proveedores presentes en París para esta próxima edición.
ASIA REGRESA A TEXWORLD EN FEBRERO
Se espera que la edición de febrero de Texworld Evolution París se acerque a los niveles anteriores a la crisis sanitaria. Cerca de 750 empresas de una veintena de países, los tres días de ex-
posición son una una oportunidad para que los visitantes puedan reencontrarse con la oferta de los grandes tejedores, bordadores y confeccionistas asiáticos.
SE CONFIRMAN LOS NIVELES PREVIOS AL COVID
Texworld París, que reúne a fabricantes de tejidos (punto bordado, jacquard, algodón, etc.), espera acoger a principios de año a unos 450 expositores de 14 países, entre ellos cerca de 250 empresas chinas.
Artículo completo en

NoticieroTextil | Diciembre 2022 19 CABECERA
Blossom Première Vision contará con unos cien expositores
Los días 14 y 15 de diciembre, el salón Blossom Première Vision, dedicado a las precolecciones de marcas de moda y accesorios creativos, de alta gama y de lujo, presentará su 10ª edición en el Carreau du Temple de París; un punto de encuentro para ver las primeras propuestas para la temporada primavera/verano 24.
Desde 2022 y el traslado al mes de julio de la edición de Première Vision Paris, organizada inicialmente en septiembre, Blossom Première Vision se ha convertido en un evento anual. Un salón, organizado ahora en diciembre que, en consonancia con el calendario de las primeras colecciones de primavera-verano (precolecciones), complementa la edición de febrero de

Première Vision Paris, que exhibe las colecciones principales.
Un centenar de proveedores de tejidos, pieles y accesorios presentarán sus colecciones exclusivas y novedades para la primavera-verano 24. Como en todos los salones de Première Vision, estos expositores han sido seleccionados por un Comité de Selección en función de sus conocimientos técnicos y de la calidad y creatividad de sus productos.
En su oferta de novedades e innovaciones, el desarrollo de materiales y procesos de producción sostenibles desempeña un papel cada vez más importante cada temporada.
NoticieroTextil | Diciembre 2022 20 CABECERA
El U.S. Cotton Trust Protocol publica su informe anual

El U.S. Cotton Trust Protocol ha publicado su segundo informe anual, donde detalla los resultados obtenidos en el período 2021- 2022. El protocolo es la primera iniciativa que establece los estándares para el cultivo de algodón sostenible en Estados Unidos y entre las cifras de su actividad durante el último ejercicio destacan la mejora en las métricas de sostenibilidad y la incorporación de nuevos miembros a lo largo de toda la cadena de suministro.
También es significativa la finalización con éxito de nueve programas piloto y el mayor reconocimiento a nivel internacional.
MEJORES RESULTADOS EN MÉTRICAS CLAVE PARA LA SOSTENIBILIDAD
Según los datos del Trust Protocol a nivel de
cultivo del algodón, los productores adheridos al programa han conseguido mejoras significativas en seis métricas clave:
• un aumento del 13% en eficiencia de uso del terreno.
• un aumento del 15% en eficiencia de uso de agua.
• una reducción del 25% en el uso de energía.
• una reducción del 21% en las emisiones de gases de efecto invernadero.
• una reducción del 78% en la pérdida del suelo
• un índice de conservación del suelo positivo en el 70% de los productores.
NoticieroTextil | Diciembre 2022 21 CABECERA
Artículo completo en
Munich Fabric Start adelanta a julio su edición de verano
A partir de 2023, el salón alemán de tejidos adelanta a julio su edición de verano. De esta forma, Munich Fabric Start , Bluezone, Keyhouse y The Source acontecerán en la segunda quincena de julio. Por su parte, View se celebrará por vez primera como reVIEW los días 5 y 6 de septiembre de 2023 tras Munich Fabric Start.
En cambio, las fechas de la feria para primavera-verano 24 se mantienen sin cambios: View (29 – 30 de noviembre de 2022), Munich Fabric Start (24 – 26 de enero de 2023), Bluezone y Keyhouse (24 – 25 de enero de 2023).
“Munich Fabric Start Exhibitions GmbH se asegu-
ra una fecha estratégicamente importante en la segunda quincena de julio a partir del verano de 2023 y adelanta seis semanas sus principales eventos. En concreto, Munich Fabric Start tendrá lugar por primera vez en su nueva fecha del martes 18 al jueves 20 de julio de 2023. El lugar seguirá siendo el MOC de Múnich”, remarcan sus organizadores. Por su parte Bluezone, Keyhouse y The Source, en el recinto del Zenith, se desarrollarán como eventos de dos días (18 y 19 de julio de 2023).

completo
NoticieroTextil | Diciembre 2022 22 CABECERA
Artículo
en
Aitpa entrega sus Premios a la Innovación
La Asamblea General de AITPA ha sido el marco para la entrega de los Premios a la Innovación 2022.
En la VIII edición de los Premios de Innovación al Talento Joven de AITPA , el jurado ha concedido los siguientes premios:

PRIMER PREMIO A LA INNOVACIÓN AITPA 2022
a Jordi Soler Molina por su trabajo Estudio y desarrollo de un nuevo proceso de tintura mediante celulosa nanofibrilada (NFC).
“Por la calidad de su trabajo en diversas dimen-
siones, desde la claridad en la exposición de los objetivos hasta la precisión en la reflexión y la evaluación de los resultados obtenidos. Es una buena muestra del tesón del sector textil en la continua investigación de métodos de tintura que optimicen el consumo de recursos, para ser más sostenibles desde los inicios de la cadena de valor. Las cifras de reducción de agua en el consumo de agua son altamente esperanzadoras”, subrayan desde Aitpa.
Jordi Soler Molina recogiendo el galardón
NoticieroTextil | Diciembre 2022 23 CABECERA
Artículo completo en
INVESTIGACIÓN DE LA MEJORA DE LA HIDROFILIDAD INHERENTE EN FIBRAS POLIMÉRICAS Y SU COMPATIBILIZACIÓN EN MEDIOS ACUOSOS PARA APLICACIONES DE REFUERZO Y SEGURIDAD
La investigación y el desarrollo en el Sector Textil Valenciano hoy en día pasa necesariamente por el desarrollo de productos técnicos de elevado valor añadido y con amplia funcionalidad, permitiendo su aplicación diversos ámbitos técnicos para favorecer su crecimiento socioeconómico.

Por ello, AITEX apuesta por el desarrollo de productos de I+D con el proyecto HIGHSPIN, como son las nuevas fibras poliméricas con un comportamiento hidrofílico mejorado, nuevas funcionalidades y mejores propiedades físico-mecánicas.
En la línea de investigación del proyecto perteneciente al sector TEXTIL-MODA, se han desarrollado tejidos transpirables de poliamida con distintas funcionalidades, todo ello destinado a mejorar la calidad y confort de las prendas deportivas y médicas.
RESULTADOS TÉCNICOS GENERALES
En el proyecto HIGHSPIN se han conseguido resultados con un elevado
grado de novedad ya que, por una parte, se han desarrollado tejidos técnicos de poliamida con elevada resistencia, buena transpirabilidad y otras funcionalidades y, por otro otra parte, se han obtenido fibrillas de polipropileno que mejoraran los aspectos funcionales, económicos y de procesado respecto a las fibrillas existentes en el mercado.
Los resultados técnicos se detallan a continuación:
• Se han obtenido nuevas formulaciones en base polipropileno y poliamida con mejor comportamiento hidrofílico y propiedades funcionales añadidas.
• Se han desarrollado hilos multifilamento con buenas propiedades mecánicas.
• Se han desarrollado hilos multifilamento con secciones especiales que mejoran la gestión de la humedad en los tejidos de poliamida (valores RET de hasta 1 m² PA/W) y en las fibrillas de polipropileno (procesabilidad mejorada).
• Se han obtenido fibras cortadas de polipropileno compatibles en medios acuosos.
• Se han obtenido hilos texturizados ATY y DTY de poliamida que mejoran la suavidad y confort en los tejidos.
• Se han desarrollado tejidos y prototipos demostradores funcionales de PA con buena transpirabilidad, resistencia mecánica y resistencia a la abrasión.
• Se ha adquirido conocimiento a partir de la caracterización de “blends”, fibras cortadas, hilos y tejidos.
RESULTADOS TÉCNICOS DIRIGIDOS AL SECTOR TEXTIL-MODA
En primer lugar, se han desarrollado hilos de con distintas secciones a partir de “blends” de poliamida funcionalizados con propiedades antibacterianas, resistencia ultravioleta y beneficios corporales.
Por un lado, se han desarrollado hilos de poliamida con sección “Trilobal

en

“Side
en Línea” capaces de transportar la humedad a través de sus canales, formando así tejidos altamente transpirables.
Por otro lado, se han obtenido hilos
Vista en microscopio SEM de la sección “Trilobal en línea” de las fibras de poliamida desarrolladas por AITEX.
Vista
microscopio SEM de la sección
by Side” de las fibras de poliamida desarrolladas por AITEX
Conjunto de ropa deportiva confeccionado a partir de los tejidos altamente transpirables desarrollados por AITEX.

de poliamida con sección “Side by Side” (bicomponente), que aporta elasticidad, evitando el uso de elastano y permitiendo la reciclabilidad del producto gracias a su ecodiseño. Además, el canal que conforman los dos componentes favorece el transporte de humedad.
Los hilos de poliamida desarrollados han sido texturizados mediante las tecnologías DTY y ATY para aportarles
suavidad y confort, obteniendo elevados valores de tenacidad, del orden de entre 3 y 4 gramos/denier.
A partir de los hilos de poliamida obtenidos, se han desarrollado tejidos transpirables de calada y punto, pasando de valores RET de 2 m2 PA/W en tejidos de calada con sección circular a 1 m2 PA/W en tejidos de calada con sección “Trilobal en línea”. Dichos tejidos ofrecen alta resistencia a esfuerzos de tracción (400N a 1 cabo en la dirección longitudinal y 800N a 2 cabos en la dirección transversal) y abrasión (con un nivel de comportamiento “A” según la norma EN 14465:2003/A1:2006).
Finalmente, a partir de los tejidos de poliamida obtenidos, se ha desarrollado un conjunto deportivo a modo de prototipo demostrador:
Las características específicas del tejido usado para la confección del prototipo son:
• Poliamida funcionalizada con nanoaditivos FIR que mejoran la microcirculación sanguínea, promueven la regeneración, y sanado de heridas y reducen la inflamación y el dolor en músculos y articulaciones.
• Hilo multifilamento con sección “Trilobal en línea” que mejora la transpirabilidad en tejidos, transportando la humedad a través de sus canales.
• Hilo texturizado mediante tecnología DTY para aportar volumen y suavidad al hilo, cuyo título fino (100 dtex) aumenta el efecto de confort.
• Tejido obtenido mediante tejeduría circular de punto para maximizar su efecto elástico.
Por todo ello, se han desarrollado productos con un alto valor añadido gracias a sus funcionalidades, transpirabilidad, confort y ecodiseño sostenible que favorecerán el crecimiento socioeconómico de las empresas de los sectores del TEXTIL MODA y AUTOMOCIÓN a nivel regional, nacional e internacional.
Este proyecto cuenta con el apoyo de
la Conselleria d’Economia Sostenible, Sectors Productius, Comerç i Treball de la Generalitat Valenciana, a través del IVACE, y está cofinanciado por los fondos FEDER (Fondo Europeo de Desarrollo Regional) de la Unión Europea, dentro del Programa Operativo FEDER de la Comunitat Valenciana 2021-2027 (IMDDEA/2021/22)
Más información aquí

El acto Somos AEQCT entrega premios y establece objetivos

La Asociación Española de Químicos y Coloristas Textiles celebró el pasado 11 de noviembre el acto oficial Somos AEQCT, con el propósito de agradecer a los socios y empresas protectoras los momentos compartidos a lo largo del período 2014-2022 y proyectarse hacia el futuro, contando una vez más con la colaboración de todos los que conforman la AEQCT.
La celebración del acto tuvo lugar en las instalaciones del recinto modernista del Hospital de la Santa Creu i Sant Pau, en Barcelona, y dio comienzo con una visita guiada a las instalaciones.

Prosiguió con el acto central en la Sala Magna
de la Casa Convalescència, haciendo alusión a distintos aspectos relevantes de la Asociación para dar paso a la entrega de premios.
Se definió como el momento oportuno para premiar a los socios y empresas protectoras por su aportación a lo largo de los años, siendo ellos los verdaderos protagonistas en el establecimiento de los objetivos que debe alcanzar la asociación frente a los nuevos desafíos.
NoticieroTextil | Diciembre 2022 28 CABECERA
Artículo completo en




Filo, dos objetivos para la innovación textil
Como motor de desarrollo y crecimiento de la industria, la innovación en el sector textil está abriendo dos caminos, ambos importantes y destinados a cruzarse.
En efecto, existe una innovación destinada a ofrecer al mercado nuevos productos. Pero también hay una innovación textil dirigida a una mayor sostenibilidad de la industria. Las dos vertientes de la innovación suelen ser el centro de los «Dialoghi di Confronto» de Filo.

Ahorrar energía o agua a lo largo de la cadena de suministro textil representa una necesidad urgente para proteger el medio ambiente, pero en tiempos de crisis energética, también representa una necesidad en relación con el presupuesto empresarial.
En este sentido, la innovación tecnológica ha desempeñado un papel esencial en el avance de la industria textil hacia procesos más sostenibles. Paralelamente, el mercado exige de la industria textil una innovación continua en la gama de productos, buscando nuevos materiales y soluciones para mejorar la calidad y aumentar el valor de los productos, junto con el bienestar de los consumidores, prestando siempre especial atención a la sostenibilidad.
Artículo completo en
NoticieroTextil | Diciembre 2022 30
SOSTENIBILIDAD
Texfor desarrolla un curso centrado en la sostenibilidad de la cadena de valor
El organismo anuncia el curso Fundamentos y tendencias de sostenibilidad en la cadena de valor de la industria textil, que arranca el 1 de diciembre de 2022 dentro de su programación en Aula Virtual, y de la mano de David Allo, responsable de Sostenibilidad de Texfor.
La séptima edición de este curso ofrece de nuevo la oportunidad a cualquier persona interesada que busque hablar de sostenibilidad, la que parte del conocimiento técnico y objetivo de los industriales.
Los asistentes se adentrarán de una forma práctica en la sostenibilidad textil para aprender de forma sencilla tendencias en materia de

desarrollo de producto, blockchain, normativas, legislación, descarbonización, requerimientos de cliente, zero waste, zero water, REACH, etc.
Adquiriendo conocimiento sobre la importancia de la sostenibilidad y la implicación de los diferentes actores industriales (hilaturas, tejedurías, tintura y acabado de tejido, estampación, etc.) y otros actores clave (Clientes, Certificadoras, ONG’s, Administraciones, Organismos Internacionales…).
Artículo completo en
NoticieroTextil | Diciembre 2022 31
Riopele sigue avanzando en sus objetivos en sostenibilidad
La compañía portuguesa, fundada en 1927 por José Dias de Oliveira y establecida en Pousada de Saramagos, es una de las empresas textiles más antiguas de Europa, y está dedicada a la creación y producción de tejidos para moda.
En la actualidad, dirigida por José Alexandre Oliveira, nieto del fundador, está focalizada en una carrera para ser lo más sostenible posible, entre otras formas con la conversión de sus residuos textiles en nuevos tejidos. Con todo, el gran reto de la compañía es reducir estos residuos textiles y que en 2025 un 80% de sus productos sean sostenibles.

Albertina Reis, directora de I&D de Riopele, asegura que “ahora es más fácil hablar de sostenibilidad, ya que desde la pandemia los clientes están más involucrados con este concepto”. En este sentido, la compañía dispone de todas las certificaciones existentes para garantizar la transparencia ante sus clientes.
Artículo completo en
NoticieroTextil | Diciembre 2022 32 SOSTENIBILIDAD
Greenpeace saca a la luz los trapos sucios de SHEIN

Greenpeace saca a la luz los trapos sucios de SHEIN analizando 47 prendas de la marca. En ellas ha encontrado sustancias químicas tóxicas, peligrosas para la salud y el medioambiente.
Además, Greenpeace advierte que muchas empresas de moda radicadas fuera de la Unión Europea no cumplen con el reglamento sobre sustancias químicas peligrosas en productos importados (Reglamento REACH), que establecen límites de concentración estrictos.
INFORME DE GREENPEACE SOBRE SHEIN
Según el último informe de Greenpeace, la marca de moda SHEIN tiene un modelo de negocio basado en químicos peligrosos y destrucción ambiental.
Greenpeace ha analizado las sustancias químicas en 47 productos de la marca, y ha encontrado que siete contenían sustancias químicas peligrosas que superan los límites reglamentarios
de la UE. Además cinco de estos productos superan los límites en más de un 100 %. Según las pruebas, 15 artículos contienen sustancias químicas peligrosas en niveles preocupantes por encima del certificado OEKO Tex .
Greenpeace compró 42 artículos, incluidas prendas y calzado de las páginas web de SHEIN en diferentes países europeos. También adquirió cinco artículos de una tienda ’pop-up’ en Alemania. Los productos fueron enviados a un laboratorio independiente para su análisis químico. Los hallazgos, que incluyen niveles muy altos de ftalatos en los zapatos y formaldehído en el vestido infantil, demuestran la actitud negligente de la marca respecto a los riesgos ambientales y la salud humana asociados con el uso de sustancias químicas peligrosas.
Artículo completo en
NoticieroTextil | Diciembre 2022 33 SOSTENIBILIDAD
Foto: Ferran Nadeu
“Hay que ayudar a los trabajadores a adaptarse a las nuevas tecnologías mediante el reciclaje profesional”
Nuestro entrevistado fue elegido presidente de CEMATEX-Comité Europeo de Fabricantes de Maquinaria Textil y propietario de ITMA e ITMA ASIA- en junio de 2020, un momento en el que la pandemia mostraba su peor rostro en todo el mundo, obligando a suspender de forma indefinida todos los eventos. Por suerte, la situación ha cambiado y la considerada “Olimpiada” de las exposiciones de maquinaria textil se prepara para una brillante edición en Milán del 8 al 14 de junio de 2023 y sobre la que Maurer desgrana todo tipo de detalles en esta entrevista
FRANCESC M. ALMENA / JOSÉ MARTIN, Barcelona
PRESIDENTE NoticieroTextil | Diciembre 2022 34
DE CEMATEX ENTREVISTA
ERNESTO MAURER
¿Qué le llevó a reorientar su carrera del sector energético al textil? Dada la situación actual, ¿se equivocó o acertó?
Como siempre en la vida empresarial, las oportunidades van y vienen; habrá algunas que se aprovechen y otras que no. La oportunidad de entrar en el sector textil me llegó en 1992; la aproveché, y desde entonces no hay vuelta atrás. Tanto el sector energético como el textil tienen su cuota de oportunidades y desafíos.
Hoy en día, nos preocupa el cambio climático y la economía circular, así como la crisis energéti-
ca. A pesar de los retos, ha sido un viaje gratificante para mí. Me alegro de poder contribuir a la industria textil a través de mi participación en Swissmem y CEMATEX. La alimentación, la energía, el textil, la sanidad y el transporte son cinco de los sectores más destacados, y he tenido el honor de servir en dos de ellos.
¿Cuánto tiempo lleva como presidente de Cematex? ¿Qué era Cematex antes de Ernesto Maurer y cuál será su legado?
Fui elegido para ser presidente de CEMATEX en junio de 2020 por un periodo de cuatro años. Actualmente, estoy a mitad de mi mandato. Dado que la política de exposiciones es el negocio principal de CEMATEX, estoy dirigiendo a Cematex en un período difícil.

Durante la pandemia de coronavirus, se han cancelado o pospuesto exposiciones presenciales en todo el mundo. Esto afectó a nuestra feria combinada en Shanghai: la ITMA Asia + CITME en Shanghái en 2020 y 2022 tuvo que ser pospuesta.
Por otra parte, nuestra próxima exposición ITMA, que se celebrará en Milán del 8 al 14 de junio de 2023, ha recibido una fuerte respuesta de los expositores; sólo quedan bolsas de espacio en uno de los 12 pabellones. Para complementar nuestra exposición presencial, hemos puesto en marcha una plataforma de negocios en línea que permitirá a los participantes comprometerse antes y después de la exposición física.
Como presidente de la Asociación Suiza de Maquinaria Textil, ¿cómo definiría el panorama del país en ese ámbito?
La Asociación Suiza de Maquinaria Textil (Swissmem) se fundó en 1940 (al borde de la Segunda Guerra Mundial) y ha superado varias crisis. Desde entonces, la asociación se ha fortalecido y constituye un importante pilar en el marco más amplio de los productores europeos de maquinaria textil.
Hoy en día, la maquinaria textil suiza ocupa una posición de liderazgo en el segmento
NoticieroTextil | Diciembre 2022 35 ENTREVISTA
Ernesto Maurer
de máquinas especiales y materiales de alta calidad. En la actualidad, contamos con 45 empresas miembros, entre las que se encuentran fabricantes de máquinas y componentes, y proveedores de servicios que ofrecen soluciones que cubren toda la cadena de valor textil.
A pesar de los enormes retos a los que se enfrenta la industria textil, estoy seguro de que la industria suiza de maquinaria textil seguirá siendo una fuerza poderosa e influyente en estos tiempos tan exigentes.
¿Cuál es la situación de la maquinaria textil en Europa? ¿Hay planes para incorporar más asociaciones europeas además de las nueve existentes?
La tecnología textil europea está bien representada en todos los segmentos de la cadena de valor del sector textil y de la confección, especialmente en los sectores tradicionales de la hilatura, la tejeduría y el punto, así como en las áreas cada vez más importantes de los materiales avanzados, el reciclaje y las fibras e hilos reciclados.
La innovación forma parte de nuestro ADN y se están llevando a cabo muchas investigaciones y desarrollos en y entre grupos industriales, instituciones y empresas. Por ello, el sector europeo de la maquinaria está bien situado para ofrecer las soluciones digitales y de automatización más sofisticadas, así como tecnologías sostenibles. Muchas de estas innovaciones se presentarán en la próxima feria ITMA de Milán.
Por el momento, no hay planes para añadir nuevas asociaciones a CEMATEX.
Faltan pocos meses para la 19ª edición de la ITMA de Milán. ¿Cuáles cree que serán las aportaciones más importantes del evento?
Será la primera gran exposición de la industria textil y de la confección que se celebre después de la pandemia de coronavirus. Creemos que el sector está deseando que se produzcan interacciones cara a cara en Milán.
una
no
El tema de la ITMA 2023 es Transformar el mundo del textil. Está subrayado por cuatro temas de tendencia: automatización y futuro digital, materiales avanzados, sostenibilidad y circularidad, y tecnologías innovadoras. Muchos expositores mostrarán sus últimas innovaciones en toda la cadena de valor de la fabricación que ayudarán a los fabricantes de textiles y prendas de vestir a ser más competitivos, así como a ser más sostenibles y circulares.
La ITMA no es solo una plataforma de lanzamiento de tecnología innovadora, sino también un lugar en el que las empresas se relacionan y colaboran. Con un mayor énfasis en la colaboración entre las diversas partes interesadas, la ITMA 2023 presentará grandes oportunidades para el diálogo y el intercambio de conocimientos entre los grupos de la industria.
En los últimos años, el éxito medido en cifras es abrumador. Casi 1.700 expositores. Más de 100.000 mil visitantes. Casi 114.000 metros cuadrados de superficie de exposición. ¿Podrá Milán 2023 acercarse, igualar o superar estas cifras?
La pandemia ha afectado negativamente a las empresas, incluidas las de la industria textil y de la confección. Estamos muy agradecidos
NoticieroTextil | Diciembre 2022 36 ENTREVISTA
“ITMA
es solo
plataforma de lanzamiento de tecnología innovadora, sino también un lugar en el que las empresas se relacionan y colaboran”
por el apoyo de la industria. Aunque no alcancemos el número de expositores de 2019, nos alegramos de que los expositores reserven más espacio. En términos de espacio neto de exposición, hemos superado el tamaño de 2019.
En cuanto al número de visitantes, no empezamos el registro de visitantes en línea hasta finales de noviembre. Por lo tanto, es difícil prever las cifras, ya que hay muchos factores que pueden afectar al número de visitantes del próximo año.
Ha habido muchas ITMA a lo largo de la historia. Desde la de 1951 en Lille, la muy criticada de 1967 en Basilea hasta las muy brillantes y recientes de Milán y Barcelona. ¿Cómo definiría el camino recorrido durante estos setenta y dos años de existencia?
La ITMA, que se celebra cada cuatro años, está considerada como la Olimpiada de las exposiciones de maquinaria textil. A lo largo de
las últimas décadas se ha convertido en la plataforma definitiva para conocer las tendencias futuras de la industria. En ella, los fabricantes muestran a un público mundial las tecnologías y soluciones más avanzadas para todos los aspectos de la cadena de valor del sector textil y de la confección.
Organizada por la industria para la industria, la ITMA ha sido capaz de preservar su propuesta de venta única que le ha ayudado a mantener su reputación y calidad. Sólo permitimos exponer a los fabricantes y a los titulares de la propiedad intelectual, los expositores deben hacer demostraciones de maquinaria en vivo, deben estar agrupados en sectores para facilitar la búsqueda de proveedores, y otras características definitorias.
La ITMA también ha evolucionado con los tiempos, y sigue reinventándose para ser una plataforma relevante para la industria textil. En cada edición, revisaremos el índice de productos. También hemos introducido el

NoticieroTextil | Diciembre 2022 37
Premio a la Innovación Sostenible de la ITMA desde 2011 para poner de relieve la causa de la sostenibilidad.
Además, hemos puesto en marcha varias iniciativas del sector, como los foros de telas no tejidas y de colorantes y productos químicos, en los que colaboran asociaciones del sector, y hemos concedido subvenciones a instituciones de investigación y a empresas de nueva creación para que muestren sus proyectos e innovaciones, respectivamente.
El salón comenzó mostrando casi exclusivamente máquinas y tecnología para la hilatura, la tejeduría y el acabado. Con el paso de los años, la ITMA ha evolucionado para ofrecer una amplia gama de productos y servicios en las últimas ediciones. La razón... ¿mejorar los beneficios? ¿reemplazar eventos que ya no existen? ¿ofrecer soluciones tecnológicas verticales para complejos industriales verticales?

Para garantizar que la ITMA siga siendo una plataforma industrial relevante, revisamos el índice de productos de cada edición. Debido al desarrollo de las tecnologías y a la evolución de las necesidades de fabricantes y consumidores, vemos que se lanzan muchas innovaciones.
En el pasado, los productos textiles se destinaban principalmente a la confección y a los textiles para el hogar. Hoy, sin embargo, los
la ITMA 2023 se expondrán soluciones de reciclaje de aguas residuales”
textiles técnicos y no tejidos se utilizan para diversas aplicaciones, desde la agricultura hasta la construcción y la industria aeroespacial. Además, cada vez hay más colorantes y productos químicos nuevos y mejores, así como tecnologías de acabado y reciclaje. De ahí que tengamos que garantizar que el índice de productos sirva a los intereses de nuestros miembros y sus clientes.
La globalización de la industria ha proporcionado oportunidades a los principales fabricantes para hacer crecer su negocio de forma vertical u horizontal, de modo que puedan ofrecer una solución única a las principales marcas. Por lo tanto, la ITMA también se ha expandido en paralelo para atender a estos fabricantes.
Al ofrecer a la industria textil una plataforma integral de comercialización y abastecimiento, hemos introducido fibras, hilos y tejidos. También para facilitar la creciente colaboración entre
NoticieroTextil | Diciembre 2022 38
“En
los proveedores de materiales y los fabricantes de maquinaria. En esta edición, hemos lanzado los compuestos textiles, ya que el mercado de los materiales avanzados ofrece interesantes perspectivas a los fabricantes de textiles.
Ha sido un espectador privilegiado en la evolución del sector y también en los cambios tecnológicos que han llevado al sector a producir más, más rápido y más rentable. Sólo hay que pensar en lo que producía un telar en los años cuarenta y cincuenta del siglo pasado con lo que produce hoy tanto en metros tejidos como en número de personas que acuden a él. Pero... el mundo actual tiene grabado un término que se pronuncia cada día .... Sostenibilidad... entonces ¿por qué máquinas que producen más, sistemas que eliminan puestos de trabajo?... ¿No es todo esto una contradicción?
Las nuevas tecnologías de producción han cambiado fundamentalmente las condiciones de trabajo y el estilo de vida de las personas. Hoy en día, la adopción tecnológica es uno de los factores más importantes que está remodelando activamente los puestos de trabajo en muchas partes del mundo. A medida que el impacto de la automatización se extiende a los puestos de trabajo de alta y baja cualificación, son los puestos de trabajo de baja cualificación los que se sustituyen por una producción más rápida y eficiente impulsada por máquinas, especialmente en el sector de la confección.
Aunque las tecnologías de automatización provocarán una pérdida considerable de puestos de trabajo en la industria, algunos creen que un resultado probable es una mayor colaboración entre trabajadores y máquinas. También crea un trabajo de mayor valor, y oportunidades para la formación de habilidades. Las empresas, la industria y los gobiernos deben colaborar para ayudar a los trabajadores a adaptarse a estas nuevas tecnologías mediante el reciclaje profesional y los cambios de carrera.
Siguiendo en esta línea, y pensando en el mundo a medio plazo, en el ámbito de los
acabados, ¿veremos algo en Milán que nos haga intuir que por fin se ha valorado realmente el agua?
Se calcula que la producción textil es responsable de casi el 20% de la contaminación mundial por agua limpia procedente de los productos de tintura y acabado.
En el ámbito de los acabados textiles, la investigación y el desarrollo se han intensificado a medida que los problemas de sostenibilidad se han hecho más acuciantes. Habrá expositores que presentarán tecnologías innovadoras, como la tecnología de tintura textil de bajo consumo y sin agua.
También se expondrán procesos de ahorro de agua de última generación y nuevos colorantes y productos químicos que reducen el tiempo de procesamiento, lo que ayudará a las fábricas a reducir el agua y la energía necesarios para la producción.
Al mismo tiempo, en la ITMA 2023 se expondrán soluciones de reciclaje de aguas residuales, así como fibras y materiales reciclados que contribuyen a la causa de la sostenibilidad.
Barcelona, Milán, Barcelona, Milán. En los últimos doce años, estas dos ciudades latinas han monopolizado la celebración del evento. Es cierto que cuentan con instalaciones suficientes para acoger el evento. ¿Continuará ITMA celebrando su evento siguiendo este modelo?
Como en todas las ediciones de ITMA, invitamos a presentar ofertas a todas las sedes europeas adecuadas que dispongan de espacio suficiente para albergar nuestra exposición, que requiere al menos 200.000 metros cuadrados, y unas instalaciones técnicas sólidas que permitan realizar demostraciones de maquinaria en vivo. La carrera siempre está abierta, y el hecho de que hayamos contado con Milán y Barcelona repetidamente en poco tiempo indica la fuerza relativa de estos dos recintos. Veamos qué nos depara el futuro.
NoticieroTextil | Diciembre 2022 39 ENTREVISTA
ROPA DE CASA
Heimtextil selecciona los productos para los visitantes del sector contract
Se ha realizado la selección de los productos que se mostrarán en la Heimtextil Interior.Architecture.Hospitality Library. El 30 de noviembre de 2022, un jurado de expertos eligió los textiles funcionales que se presentarán en la Library de Heimtextil 2023. Se seleccionaron 85 expositores entre el gran número de entradas y mostrarán sus productos en el elaborado escenario de la Library en el pabellón 4.0. Los textiles estarán marcados con el nombre y el número de stand de los fabricantes correspondientes.

La nueva edición de la Library de materiales para textiles funcionales que se celebrará a principios del año que viene se centrará en cinco características diferentes: ignífugo, absorbente
del sonido, resistente a la luz, antimicrobiano y repelente al agua.
A la hora de hacer la selección, los expertos tuvieron en cuenta no sólo la funcionalidad, sino también el diseño y la innovación. Con Gerhard Sperling , Verband der Deutschen Heimtextilien-Industrie e.V., Jasmin Grego, Grego Jasmin Grego & Stephanie Kühnle Architektur GmbH, y Felix Diener, Marburger Tapetenfabrik, el jurado combinó la experiencia de un ingeniero textil con la de dos expertos en aplicaciones.
Artículo completo en
NoticieroTextil | Diciembre 2022 40
Wow your senses.
The true TEXTILES-TRENDS-TALKS experience.
Inspire a sus sentidos: En la feria internacional más influyente de textiles para el hogar y proyectos contract, con las tendencias, conferencias y visitas guiadas más actuales - para los profesionales del textil ávidos de conocimiento. Establezca nuevos contactos profesionales y obtenga una visión integral del mercado. Todo ello en un plazo de pocos días –solo posible en Heimtextil con su efecto WOW.

10 – 13. 1. 2023 FRANKFURT/MAIN
informado y suscríbase en nuestra Newsletter!
messefrankfurt.com Tel. +34
5 33 76 45
Manténgase
info@spain.
91
www.heimtextil.messefrankfurt.com
Home Textiles Premium by Textilhogar anuncia las fechas de su próxima edición
El certamen especializado en hogar, tapicería y decoración, Home Textiles Premium by Textilhogar, ha marcado sus fechas en el calendario internacional de ferias del sector, del 19 al 22 de septiembre de 2023. La cita consolida su celebración en Valencia junto a Feria Hábitat Valencia como el principal escaparate para la decoración del hábitat.

Tras el éxito de su pasada edición, que recibió a más de 48.000 visitantes profesionales y más de un millar de firmas expositoras, HTP by Textilhogar trabaja con el objetivo de potenciar, más si cabe, su internacionalidad. Ya en 2022, profesionales de 44 países con un alto poder de compra y prescripción, conocieron de primera mano el made in Spain
Para su próxima convocatoria, el certamen po-
tenciará las acciones para atraer a compradores involucrados en los diferentes segmentos del sector textil-hogar, tanto los canales tradicionales de distribución como la prescripción para proyectos contrat.
La feria, que celebrará su séptima edición, volverá a reunir una oferta expositiva donde descubrir las últimas novedades en diseño, tendencias e innovación para la decoración de interiores tanto en el segmento tradicional como residencial, hotelero, oficina o restauración.
Artículo completo en
NoticieroTextil | Diciembre 2022 42 ROPA DE CASA
Si estás viendo este anuncio...

audiencia también
...tu
+Info 678 48 60 68 info@noticierotextil.net
PORTUGAL MADE IN
KIDS
MODAPORTUGAL,
juntos por un futuro mejor
#togetherforthefuture
La iniciativa KIDS MODAPORTUGAL ha sido lanzada por el CENIT -Centro de Inteligencia Textil y la Asociación ANIVEC- La Asociación Portuguesa de Industrias de Vestuario y Confección, para divulgar a nivel internacional el dinamismo y diversidad de las marcas portuguesas de moda infantil que operan en el mercado global.
Aunque la campaña se enfoca en ocho marcas que son muy representativas de la oferta de Portugal en este subsector, el concepto abarca a más de 50 firmas que con su creatividad y saber hacer conforman la oferta exportadora de este segmento en el que el amor por las ma-
terias primas naturales y la sostenibilidad son el eje conductor de sus valores como marcas y la filosofía común que comparten y les distingue.
KIDS MODAPORTUGAL se enfoca en destacar a ocho marcas portuguesas que, con su compromiso por la sostenibilidad, ponen cara y ojos a este movimiento: Baby Gi , Knot , Laranjinha , Play Up, Pureté , Snug , Wedoble y Wolf&Rita representan a este universo de marcas para las que el impacto positivo que la moda ha de tener en el medio ambiente, en las personas y en la economía son valores esenciales de sus firmas y, por ende, de esta campaña.

NoticieroTextil | Diciembre 2022 44
TOGETHER
FOR THE FUTURE o JUNTOS POR
UN FUTURO MEJOR son los lemas en inglés y en español que expresan ese compromiso y que implica también unidad de acción, apoyo mutuo y esperanza en un futuro mejor, el de los niños, como puede ver en la web https://www.kidsmodaportugal.pt/
La industria portuguesa del textil y de la confección está en un momento de transformación, sino de una auténtica revolución, con el uso de nuevos materiales, cambio de procesos y con la aplicación de nuevas tecnologías, que contribuyan a los objetivos de mayor eficiencia, de reducción del impacto medioambiental, y un decidido refuerzo de la economía circular.

Esta industria sigue siendo hoy uno de los motores de desarrollo e innovación en Portugal, y el subsector de moda infantil es uno de los más dinámicos en el lanzamiento de marcas y en su fuerte componente exportador, pues se estima que solo el 16% de esta producción se destina al mercado interno, siendo el resto exportado a numerosos países, y con un volumen estimado de ventas de 600 millones de euros.

Esta campaña lanzada por el CENIT – en colaboración con ANIVEC – esta cofinanciada por el Fondo Europeu de Desenvolvimento Regional, a través del Programa Operacional de Competitividade e Internacionalização Portugal 2020.
Para mas información sobre las marcas ver https://www.kidsmodaportugal.pt/ https://www.kidsmodaportugal.pt/campaigns/ together-for-the-future Marcas
Baby
Knot Laranjinha Play Up Pureté Snug Wedoble Wolf & Rita NoticieroTextil | Diciembre 2022 45
:
gi
Amalia Home Collection, la ropa de cama más sofisticada del mundo

Amalia Home Collection es una marca de la empresa portuguesa ACL Impex , fundada en 2002 por la familia Coelho Lima, y con un crecimiento constante de 2 dígitos en los últimos 20 años. Certificada con Oeko-Tex y Algodón Egipcio™ (Gold Seal), trabaja con una gran variedad de fibras de alta gama como cachemira, seda natural, algodón Supima® y Lino.
Pero Amalia Home Collection es también la culminación de 100 años de experiencia familiar en la industria del textil para el hogar. Cuatro generaciones de una familia portuguesa han unido todo su conocimiento con una innovación constante, creando tejidos y diseños magníficos para dar respuesta a las exigencias del mercado. Desde 1922 han diseñado y fabricado la ropa de cama más sofisticada del mundo. La marca Amalia surge por iniciativa de Sara Coelho Lima , que pertenece a la cuarta generación de la familia Coelho Lima, de Guimarães.
Sara destaca la pasión por el producto como un factor diferenciador. “Nuestros productos son reconocidos a nivel mundial por su calidad y diseño, que nos llena de orgullo”. La “portugalidad” es el tema principal de sus colecciones de ropa de
cama inspiradas en la cultura y los paisajes portugueses: “Nuestra tradición es la principal fuente de inspiración, pero reinventamos patrones y colores para ir al encuentro de nuestros clientes”.
Amalia Home Collection opera en el segmento de lujo, y est á presente ya en 24 países, destacando los Estados Unidos de América, así como Europa y Asia. Se puede encontrar en las tiendas y Dep. Stores más reconocidas a nivel mundial, como Harrods (Inglaterra), Bloomingdale’s (USA y Dubái), Saks Fith Avenue (USA), El Corte Inglés (España y Portugal), entre otras.
Para António Coelho Lima , cofundador y director ejecutivo de Amalia Home Collection , el legado de su padre y de su abuelo han sido fundamentales en su negocio: “Sentido de humildad y un respeto por el ser humano muy grande… crear un ambiente de trabajo en que todos participen y sean parte del proyecto. Ese es el legado que intentamos promover hoy: que toda la gente se sienta parte de la empresa y que el éxito sea compartido”.
https://global.amaliahomecollection.com/ +351 915 374 227 | isabel.juncal@acl-home.com Facebook | Instagram | Pinterest
NoticieroTextil | Diciembre 2022 46 PORTUGAL MADE IN
Benedita Formosinho, la moda femenina intemporal
Esta marca de moda creada por la joven diseñadora portuguesa Benedita Formosinho, se caracteriza por sus prendas atemporales, sus propuestas minimalistas y la calidad de sus materias primas, utilizando siempre tejidos nobles, autóctonos y hechos con técnicas que hablan también de la historia y la emoción creativa.
Enfocada en la sostenibilidad como base de su producción, siempre ética y hecha en Portugal, cada prenda combina el diseño contemporáneo con el saber tradicional, con propuestas que se convertirán en pieza “esencial” de cada armario y podrán permanecer en él por mucho tiempo. Ropa hecha con amor, con respeto por las personas, con cuidado en cada detalle…
Formada en diseño de moda por la F. de Arquitectura de la Universidad de Lisboa, en 2018 abre su taller en Setúbal, con un ambiente abierto a la creatividad y a la transparencia como valores propios de su marca
En 2020 abre un nuevo espacio en Lisboa y crece su presencia en tiendas multimarca, tanto en Portugal como en Francia, Alemania, Austria y Canadá. Su compromiso con la moda ética ha sido positivo y motivador de su buena acogida en distintos países y culturas.
Una fase fundamental en su proceso creativo son las materias naturales, sostenibles y de bajo impacto medioambiental que utiliza, y en su mayoría procedentes de fábricas portuguesas certificadas.
Le gusta utilizar materias autóctonas y fruto de la labor de artesanos locales, como son el junco, el Burel de lana y las mantas portuguesas, como las de la Fabrica Alentejana de lanificios, respetando su autenticidad.
Trabaja también con algodón orgánico, lino, seda, lana, cupro o lyocel y con reciclados de desperdicios de su proceso de corte, a los que
da una nueva vida. Incorpora la innovación con materias primas creadas para ayudar al medio ambiente, como el tejido de gabardina NewLifeTM , hecho con hilados de residuos de botellas de plástico post consumo y sin sustancias químicas, y por supuesto, made in Portugal
El mundo de Benedita Formosinho es un viaje de inspiración y de emoción, con un estilo intemporal y responsable, con prendas cómodas y elegantes, versátiles y sostenibles, diseñadas y hechas en Portugal.
 Website | Instagram
Website | Instagram
NoticieroTextil | Diciembre 2022 47 PORTUGAL MADE IN
MODA
La gran semana del lifestyle vuelve en febrero a Ifema Madrid

El calendario del sector lifestyle ya puede marcar en rojo la primera semana de febrero en la que se celebrarán, conjuntamente, las ferias Intergift , Bisutex, Madridjoya y Momad en Ifema Madrid Todas estas citas ya han comenzado el periodo de inscripción para las firmas que quieran estar presentes en este importante momento para el sector.
La coincidencia de Intergift, Bisutex, Madridjoya y Momad se presenta como la oportunidad perfecta para generar nuevas sinergias entre firmas y marcas de distintos sectores que tienen tanto
en común. Así lo refleja el hashtag con el que aúnan la campaña de comunicación, #sumandotendencias, que será el más fiel reflejo de las cuatro ferias, y un impulso a los resultados que ya en su pasada edición de septiembre alcanzó las cifras de cerca de 35.000 visitantes profesionales y más de 1.300 empresas de 14 países participantes en las cuatro ferias.
NoticieroTextil | Diciembre 2022 48
Artículo completo en C M Y CM MY CY CMY K

En coincidencia con Profesional Feb Recinto Ferial ifema.es 03-05 2023 Salón Internacional de Moda, Calzado y Accesorios.
Carlota Barrera, Premio Madrid Capital de Moda 2022

Carlota Barrera, firma integrada en la Asociación Creadores de Moda de España (ACME), ha obtenido el Premio Madrid Capital de Moda 2022, otorgado por Madrid Capital de Moda, plataforma del Ayuntamiento de Madrid para impulsar iniciativas de moda, arte, decoración y gastronomía celebrados en la capital y potenciar además la visibilidad mundial de la ciudad.
Carlota Barrera recoge con mucha ilusión este reconocimiento: “Es todo un privilegio y es muy emocionante haber recibido el Premio Madrid Capital de Moda y tenemos muchísimas ganas de materializar este proyecto. Nuestra propuesta refleja nuestros valores fundamentales como equipo, y con el apoyo de este premio podremos desarrollar ideas que llevábamos planteando desde los inicios de la marca”, afirma la diseñadora.
Nacida en Gijón y afincada en Londres, Carlota Barrera estudió en el Instituto Europeo de Diseño y posteriormente realizó un máster de moda
masculina en el College of Fashion de la capital británica.
Premiada con el Who’s on Next de Vogue en 2019, sus piezas ofrecen una visión contemporánea de los básicos, todos creados con tejidos de calidad para asegurar su durabilidad y caracterizados también por pequeñas aberturas y deconstrucciones, una de sus señas de identidad, así como su compromiso por la sostenibilidad, la igualdad, la visibilidad de diferentes causas sociales y la evolución de los roles de género. Actualmente, presenta sus colecciones en London Fashion Week, Mercedes-Benz Fashion Week Madrid y Madrid es Moda.
Artículo completo en
NoticieroTextil | Diciembre 2022 50 MODA
Maroc in Mode ultima preparativos para su edición en Tánger
Para apoyar el desarrollo internacional de sus miembros y promover la oferta textil marroquí, la Asociación Marroquí de Industrias Textiles y de la Confección (AMITH) organiza la feria Maroc in Mode, cuya 19ª edición se celebrará del 14 al 16 de diciembre de 2022 en Tánger (Marruecos).

La exposición del MIM introduce importantes cambios en su 19ª edición:
CAMBIO DE IMAGEN
La renovación del MIM comienza con una nueva carta gráfica, dinámica y moderna.
CAMBIO DE PARADIGMA
Hoy en día, la responsabilidad social y medioambiental es una preocupación central para todos
los sectores. Esta constatación confirma las elecciones realizadas por el sector textil y de la confección marroquí para su desarrollo, priorizando la sostenibilidad en todos sus aspectos, social, medioambiental y económico.
LA PRÓXIMA EDICIÓN DE MIM SERÁ «DAYEM»
[DAYEM] (adj): sostenible en árabe: una industria textil marroquí que aprovecha su saber hacer histórico para satisfacer las necesidades del presente sin comprometer la capacidad de las generaciones futuras para satisfacer las suyas.
Artículo completo en
NoticieroTextil | Diciembre 2022 51 MODA
El certamen británico Moda contará con más de trescientas marcas
La feria de moda más antigua del Reino Unido desarrollará su próxima edición del 5 al 8 de febrero de 2023 en el NEC de Birmingham en dos pabellones y con cuatro sectores claramente definidos: moda femenina, calzado, accesorios de moda, y joyería y relojería.

Los asistentes podrán ver las últimas colecciones de más de 300 marcas tanto británicas como internacionales, incluyendo nuevos nombres.
El certamen contará con desfiles de moda y seminarios. Además, los visitantes también se beneficiarán del acceso a Spring Fair.
En el ámbito de la Moda femenina, los visitan-
tes podrán conocer lo más novedoso de marcas como Jayley, One Hundred Stars, Saloos, Fika, Lighthouse Clothing, Jessica Graaf, Soyaconcept, UbU Clothing o Cottonreal, entre otras muchas.
Por su parte, en Calzado se darán cita nombres como Fly London, XTI, Refresh, Carmela, Chatham, Mustang, Alpe, Thomas Blunt, Lunar, Laurence Llewelyn-Bowen, Anne Michelle, Top Staka, Lazy Dogz, y muchas más.
Artículo completo en
NoticieroTextil | Diciembre 2022 52 MODA
Japón regresa a Pitti Uomo
La próxima edición de Pitti Uomo, que acontece en Florencia del 10 al 13 de enero de 2023, vuelve a tener a Japón entre sus protagonistas. Tras una ausencia forzada, el próximo mes de enero la Fortezza volverá a acoger a los diseñadores y marcas made in Japan, un actor consolidado y muy cualificado en el panorama de la moda internacional.

Y entre las participaciones internacionales especiales de esta edición destacan dos proyectos que muestran la excelencia de la moda japonesa: J∞Quality Factory Brand Project, que reúne a algunos de los mejores fabricantes japoneses, y JLIA Japan Leather Booth, un es-
caparate especial de marcas especializadas en marroquinería.
Entre las marcas japonesas que presentarán sus colecciones en Pitti Uomo 103 cabe reseñar A.B.C.L., Bemberg, Boot Black, Cohèrence, Duren, D-Vec, Flower Mountain, Fujitaka, Goldwin, Haver Sack, Ikiji, Invertere, Moonstar, Nanamica, Orbium, Subu o The Chino Revived.
Además, algunos de los más destacados grandes almacenes y minoristas japoneses ya han confirmado su presencia, como Barneys Japan, Beams, Isetan Mitsukoshi, Marubeni, Ships, Takashimaya o United Arrows.
NoticieroTextil | Diciembre 2022 53 MODA
Vuelven los premios #MomadTalentsbyISEM
Momad, el Salón Internacional de Moda, Calzado y Accesorios, vuelve a poner en marcha el concurso #MomadTalents by ISEM dirigido a las firmas que comienzan su carrera en el sector y a los nuevos diseñadores que llegan con innovadoras propuestas.

Los dos primeros ganadores estarán invitados a presentar su colección en un stand en la próxima edición de Momad, del 3 al 5 de febrero de 2023. Además, el primero de ellos tendrá la oportunidad de cursar el programa formativo Fashion and Creativity Management by ISEM en el que conocer y descubrir las nuevas oportunidades de la industria de la moda.
La inscripción de candidaturas ya está abierta desde el pasado día 17 de noviembre y se mantendrá hasta el 15 de diciembre. A partir de esta fecha, el 20 de diciembre se publicarán los finalistas y el día 22 se anunciarán los ganadores de este concurso entre los que se buscará la promoción de la originalidad, la creatividad, calidad en diseños y exclusividad.
Artículo completo en
NoticieroTextil | Diciembre 2022 54 MODA
















Cronología de Noviembre 1001 Bodas supera los diez mil visitantes convocatoria bajo una nueva dirección Code 41 registra aforo completo en todas sus actividades El Rec.0 recupera el número de visitantes prepandemia Santa Eulalia celebra sus 180 años con una exposición de diseño y confección en moda baño 2023 11 3 17 21 14 11 17 23 NoticieroTextil | Diciembre 2022 55 MODA
DISTRIBUCIÓN
El futuro del ecommerce en España
Después de un boom sin precedentes marcado por la pandemia, el comercio electrónico en España no decae, sino que se consolida como canal de compra.
Un 43% de los consumidores de ecommerce en España aumentarán sus compras digitales en comparación con el año pasado y ya son 7 de cada 10 consumidores que compran al menos una vez al mes.
Estos datos se desprenden del II estudio Veepee-IESE sobre el futuro del ecommerce en España, informe realizado por el especialista en ventas flash Veepee y la escuela de negocios IESE con el objetivo principal de conocer los hábitos de consumo de los consumidores digitales y las tendencias futuras del sector.

CIFRAS PRINCIPALES DEL ESTUDIO SOBRE ECOMMERCE EN ESPAÑA
El dato más destacado del estudio es que, a pesar de que la sostenibilidad es una preocupación creciente, hay una fuerte reticencia a asumir costes por ella. La mitad de los consumidores online en España compra y vende productos de segunda mano y un 31% utiliza habitualmente los servicios de reciclaje de ropa de las marcas.
Artículo completo en
NoticieroTextil | Diciembre 2022 56
Florentino abrirá en Barcelona coincidiendo con su sesenta aniversario
La firma fundada en 1963 por Florentino Cacheda cumple 60 años con el objetivo de cumplir una de las mayores ilusiones de su fundador: contar con una tienda propia en la ciudad en la que cursó sus estudios de confección a finales de los años 50.
El punto de venta estará ubicado en plena zona comercial de la ciudad, más concretamente en el número 264 de la Calle Valencia, entre Paseo de Gracia y Rambla Cataluña, rodeado de marcas afines y consolidadas en la ciudad.
Contará con 200 metros cuadrados de superficie en los que se expondrá la colección comple-
ta de Florentino, tanto sport como sastrería y ceremonia.
Florentino inaugura de este modo su tercera tienda en Cataluña, tras las abiertas recientemente en Lleida y Figueres, reforzando así su apuesta decidida por esta zona. Se suman además varios córners en El Corte Inglés, en las ciudades de Cornellà, Sabadell y Tarragona.
Artículo completo en

NoticieroTextil | Diciembre 2022 57
Los mayoristas madrileños celebran la III Edición de los Premios Triángulo de la Moda

El Triángulo de la Moda ha celebrado la que es ya la tercera edición de los Premios del Triángulo de la Moda. Con estos galardones, el colectivo madrileño de fabricantes y mayoristas de moda, bisutería y accesorios agradece el apoyo a personalidades e instituciones que ha recibido en el último año.
Los premiados de esta edición han sido Marta Nieto, directora general de Comercio y Consumo de la Comunidad de Madrid; la iniciativa Todo está en Madrid, representado por Concha Díaz de Villegas, directora general de Comercio y Partenariado del Área de Gobierno de Economía, Innovación y Empleo del Ayuntamiento de Madrid; Flor Blázquez, periodista de Flash Moda; y Lucía Dols, creadora y directora del medio Lucía Se Casa.
El acto, como en ocasiones anteriores, se abrió con el discurso de Montserrat Gallego, presidenta del Triángulo de la Moda. En él, quiso agradecer el apoyo que ha recibido del Ayuntamiento de Madrid: “Desde hace ya varios años, nos escuchan y permiten seguir trabajando para mantener viva la historia de nuestras tiendas y nuestros trabajadores. Ofrecer un servicio mayorista de cercanía, que tengan en cuenta las necesidades de nuestros clientes”.
Artículo completo en
NoticieroTextil | Diciembre 2022 58 DISTRIBUCIÓN
Brownie incrementa su presencia en París
La empresa de moda femenina Brownie ha incrementado su presencia en el mercado francés con la apertura de una segunda tienda propia en París. El establecimiento, que cuenta con un total de 180 m2 , se inaugurará el viernes 18 de noviembre y estará ubicado en el barrio de Le Marais, zona turística dirigida a una clientela más joven.

Por esta apertura, Brownie ha recibido el apoyo de ACCIÓ -la agencia por la competitividad de la empresa del Departamento de Empresa y Trabajo de la Generalitat de Catalunya- por medio de la Oficina Exterior de Comercio e Inversiones en París.
Así, la marca de ropa femenina inspirada en el Mediterráneo, que aterrizó en Francia en abril de 2021 de la mano de los grandes almacenes
Printemps, cuenta con un total de once puntos de venta repartidos por todo el país y prevé abrir cinco más en el período máximo de un año.
El director de Brownie, Juan Morera Ortega, explica que la marca llegó a Francia con una visión estratégica: “El mercado francés es exigente y un gran referente en el ámbito de la moda; era necesario instalarnos para poder seguir creciendo en Europa. La buena acogida nos ha permitido crecer en muy poco tiempo, ya que en poco menos de un año hemos abierto dos tiendas propias en París”.
Artículo completo en
NoticieroTextil | Diciembre 2022 59 DISTRIBUCIÓN
Hug&Clau refuerza su presencia en Sevilla con una nueva concept store

La firma continúa con su plan de expansión. Si hace apenas unos días levantaba la persiana en la céntrica calle Fuencarral de Madrid, ahora lo hace con un nuevo espacio en Sevilla, donde además ha aprovechado para reforzar su presencia a pie de calle con su nuevo boho concept store
La tienda, ubicada en la calle Rioja número 4, cuenta con 100 m2 y en ella se han seguido las líneas depuradas de la flagship madrileña, ya que la marca ha optado por un estilo mucho más minimalista donde predominan los materiales
orgánicos como las maderas y plantas.
Para la inauguración ha apostado, como ya hiciera en Madrid, por un proyecto de poesía en vivo en donde diferentes poemas del artista Defreds se van sucediendo en su concepto de escaparate, que liga las colecciones de la marca con dichas creaciones artísticas y por un concurso de micropoesía al que se puede acceder a través de su web.
Con este espacio Hug&Clau alcanza ya los 17 puntos de venta físicos además de su e-commerce.
NoticieroTextil | Diciembre 2022 60 DISTRIBUCIÓN
Unisa abre una nueva tienda en Valencia con un enfoque digital

La compañía ha inaugurado el 25 de noviembre, su nuevo establecimiento en Valencia, con un concepto de tienda digital y más amplio (90m2).
Se han ampliado los metros dedicados a la exposición de producto, haciéndolo más accesible para cada cliente. En un entorno minimal, la fir-
ma alicantina sigue apostando por su servicio Custom de personalización de calzado y bolso.
Además de facilitar la compra con el Click&Collect, servicio rápido y gratuito mediante el cual comprar online una variedad de productos realizando el pago a través de la web y recogiendo el pedido en tienda física en dos horas.
NoticieroTextil | Diciembre 2022 61 DISTRIBUCIÓN
La firma de moda masculina Boston aterriza en Córdoba
La marca española de moda masculina Boston continúa con su plan de expansión por el territorio nacional y aterriza por primera vez en Córdoba con la inauguración de un córner en El Corte Inglés situado en la Avenida Ronda de Tejares, en el centro de la ciudad.

En este espacio de 34 m2 de superficie, ubicado en la planta joven, se podrá encontrar una amplia variedad de prendas de estilo casual de la firma, además de una cuidada selección de trajes, camisas y complementos de vestir.
“Córdoba es un lugar importante para nosotros, por lo que estamos muy ilusionados de abrir nuestro primer espacio. Se trata de una ciudad en conexión directa con la moda y de tradición
artesanal. El hombre cordobés ha demostrado que apuesta por la moda y confiamos en ganarnos el corazón y gusto de los cordobeses”, señala Gloria Medina , responsable de Comunicación de Boston.
De esta manera, Boston suma un establecimiento más en el territorio andaluz y refuerza su presencia en la comunidad con ocho puntos de venta, alcanzando, a su vez, un total de 31 establecimientos repartidos por todo el país .
Se trata del tercer corner que la compañía abre en la red de El Corte Inglés y no será el último. La compañía ultima los detalles para la inauguración de dos espacios más en las próximas semanas.
NoticieroTextil | Diciembre 2022 62 DISTRIBUCIÓN
Scotta 1985 abre su primera tienda propia en A Coruña
La marca española de moda masculina ha inaugurado su nueva tienda con más de 130m2 en el Centro Comercial Marinera de A Coruña


La tienda presenta un estilo decorativo juvenil y urbano, enfocado en los deportes, la diversión y el motor. Un concepto que conecta a los clientes
con la naturaleza a través del uso de materiales nobles.
En el nuevo espacio Scotta 1985 se podrán encontrar las novedades de la firma en su colección para hombre de este otoño/invierno 2022, Walking in The Snow.
NoticieroTextil | Diciembre 2022 63 DISTRIBUCIÓN
Sfero, la solución modular antihurto de Checkpoint Systems para tiendas de moda
Checkpoint Systems ha ampliado su cartera de productos con el lanzamiento de Sfero, una solución antihurto modular, con alta detección y totalmente personalizable, diseñada para que las tiendas de moda puedan minimizar los hurtos y protegerse eficazmente.
Sfero, la nueva solución antihurto de Checkpoint , se puede adaptar a cualquier tienda, gracias a su tecnología basada en RFID. Esta nueva solución permite crear una esfera de protección a partir de la combinación de pedestales inteligentes y antenas de techo. Esta esfera se puede expandir o reducir según el nivel de hurtos o de características concretas de cada establecimiento.

Este nuevo sistema permite olvidarse de los sistemas más anticuados y rígidos, y adaptar la tecnología a la necesidad de protección requerida en cada situación o a medida que el comercio crece o se transforma.
Sfero puede llegar a detectar más del 95% de las situaciones de hurto. De esta manera protege los artículos, reduciendo enormemente los robos y colaborando en maximizar ingresos.
Artículo completo en
NoticieroTextil | Diciembre 2022 64 DISTRIBUCIÓN
Yuccs sube la persiana en Barcelona
La marca de zapatillas sostenibles de lana merina avanza en su expansión retail con la apertura de su primera tienda física en Barcelona. El nuevo espacio de la Ciudad Condal se convierte en la tercera flagship de la compañía que ya está presente en Palma (noviembre de 2021) y Madrid (septiembre de 2022).

La nueva tienda insignia de la marca está ubicada en Rambla Catalunya 77, una de las principales arterias comerciales de la ciudad. El nuevo establecimiento cuenta con 130 metros cuadrados, en los que la compañía venderá sus colecciones de zapatillas de hombre y mujer, incluyendo las nuevas categorías homewear y accesorios.
Este espacio, al igual que el resto de sus flagship, cuenta con una identidad y concepto propio,
donde los materiales naturales, la sostenibilidad y la comodidad juegan un papel clave.
Esta nueva apertura se enmarca en el plan de expansión de la firma y coincide con su estrategia de diversificación de producto. Su último lanzamiento ha visto la luz este pasado 2 de noviembre: la colección de homewear Merino Slipper, las primeras zapatillas de estar por casa de la marca fabricadas con lana merina.
Para Pablo Mas, CEO y fundador de Yuccs, “la apertura en Barcelona supone un nuevo hito para la marca, ya que nos encontramos en uno de nuestros mejores momentos, con planes de nuevas inauguraciones para 2023 en ciudades estratégicas como Valencia, Bilbao, Oviedo y Sevilla y un fuerte plan de internacionalización”
NoticieroTextil | Diciembre 2022 65 DISTRIBUCIÓN
AGUILAR & PINEDA, S.L.
C. Mallorca, 279, Pral 3ª 08037 Barcelona T. 93 487 66 67 - 93 300 30 51 F. 93 488 03 75 info@aguilarpineda.es www.aguilarpineda.es













Maquinaria para hilatura, tisaje, acabados, tejidos no tejidos y accesorios. Maquinaria para laboratorio: aparatos de tintura, dispensadores, equipos de colorimetría. Software industrial. Equipos para depuración de gases y aguas residuales. Instalaciones de acondicionamiento y filtración. THINKTEXTIL

MANICH-YLLA, S.A.

Ausias March, 47 - 08010 Barcelona. T. 932 478 890 F. 932 478 891 ingenieros@manich-ylla.com Maquinaria para hilatura, tisaje y acabados. Aparatos de laboratorio para control de fibras, hilos y tejidos.
M. CASTELLÓ JOVER, S.L.
Ctra. de Pego, Km. 6,8. 03830 Muro de Alcoy (Alicante). P.O.Box 31 T. 96 553 06 11 / F. 96 553 14 78 info@hombrerasideal.com www.hombrerasideal.com Empresa certificada con el Oko Tex-Standard
Software Logística 6 5
Juan Caramuel, 1 28919
(Madrid)
del sector. Servicios: Manipulación y acabado, Logística textil, Logística in-house, eCommerce. AYB HISLABOR
A62 Pk.-148 El Montico 47100 Tordesillas - Valladolid
983 22 22 44
983 27 61 16 aybhislabor@aybhislabor.com
INDUSTRIAS WALDES SCCL Fabricante de botones y fornituras metálicas c/Ramón Turró 111-129 08005 Barcelona - España T: +34 933 093 050 comercial@waldes.es www.waldes.es
textil
Fornituras y complementos 1 4 3
C/
Leganes
Tel 912 990 001 www.thinktextil.es ThinkTextil es una compañía global con más de 15 años de trayectoria dentro
Autovía
T.
F.
www.aybhislabor.com
Maquinaria
Bordados
NoticieroTextil | Diciembre 2022 66 DIRECTORIO
Tex-Standard 100


COMERCIAL JAPSA, S.A.


Ventas y exposición: Polígono Cadesbank C/ Bilbao, 27. Ripollet 08291 Barcelona T. 933 527 456 / F. 936 921 813 japsa@japsa.es Fornituras plásticas para confección, marroquinería y bisutería. Construcción de moldes e inyección de todo tipo de piezas.







YORKSHIRE DE ESPAÑA, S.A.

P.I. Can Canals - C/ Illa de Buda, 6 08192 Sant Quirze Del Valles Barcelona Tel: 937 473 280 / Fax: 937 472 183 info@yorkshire-espana-sa.org https://yorkshire-espana-sa.com/ Yorkshire de España fue fundada en 1.968, como filial de Yorkshire Chemicals Leeds, empresa ésta centenaria en la industria química, para el desarrollo de colorantes para la industria textil, curtidos y papel. Desde la fecha de su fundación hemos estado día a día trabajando para obtener la confianza de los sectores industriales con necesidad de colorantes, ofreciendo una calidad puntera junto a un servicio ágil, rápido y esmerado.
EMILIO’S DIFUSIÓN S.L.
Ronda Sant Elm, 37 08360 Canet de Mar (Barcelona). T. 93 795 41 39 / F. 93 794 30 24 www.emiliosdifusion.com bordados@emiliosdifusion.com Bordado industrial de: cornely y lentejuelas

CENTRIC SOFTWARE



Av. Diagonal, 640, 6ª planta 08017 BARCELONA T. 932 287 806 www.centricsoftware.es






VIRTO INDUSTRIAL



Camino de la Traviesa, s/n. 47153 El Pinar de Antequera (Valladolid) T. 983 24 97 33 F. 983 24 97 34 info@virtoindustrial.es www.virtoindustrial.es Plisados - Bordados - Confección - Cinturones
480

empresarial
| Software gestión
Vía Augusta 13-15 Barcelona 08006 T. 93 415 40 05 info.erp@cuatroochenta.com www.ekamat.es/erp-textil-moda/
2
Química textil
NoticieroTextil | Diciembre 2022 67
Sprinter abre tienda en el nuevo Open Mall Lanzarote

Abre sus puertas el centro comercial Open Mall Lanzarote, ubicado en la Avenida Medular de Arrecife, y Sprinter, el retailer deportivo multimarca, inaugura tienda en este nuevo espacio.
Una apertura que suma una superficie total de 919 m2 , 662 de los cuales dedicados a superficie de venta, y que ha dado trabajo a 23 personas que se suman a este nuevo proyecto en la isla. Esta apertura es la cuarta tienda en Lanzarote, con un total de 19 en Canarias, y la número 202 en toda España.
“La tienda de Open Mall es una de las que llamamos elevadas, con una visión más actualizada del resto de tiendas de Sprinter y que ayuda a una me-
jor experiencia para el cliente, con nuevos objetos distribuidos por la tienda que ayudan al cliente a moverse con una comodidad y facilidad para que la visita en la tienda sea de su agrado. También se incorporan al diseño pantallas táctiles GPC en la zona de calzado para solicitar una talla o para ver si en la tienda hay talla de la zapatilla que le guste al cliente”, comenta Enrique Grau Brines, director territorial Zona Canarias, Centro y Norte de España del Departamento Retail de Sprinter.
NoticieroTextil | Diciembre 2022 68 DISTRIBUCIÓN
Artículo completo en
Noticiero Textil 284 Noviembre 2022

https://bit.ly/3VzdIKI
Noticiero Textil 282 Julio 2022


https://bit.ly/3dwYYvj
Noticiero Textil 283 Octubre 2022

https://bit.ly/3NMQvSa
Noticiero Textil 281 Junio 2022 https://bit.ly/3ABp0GK
Accede
a las ediciones virtuales de

























 Francesc M. Almena Redactor falmena@astoriaediciones.es
Francesc M. Almena Redactor falmena@astoriaediciones.es

Website | Instagram
Website | Instagram









































































